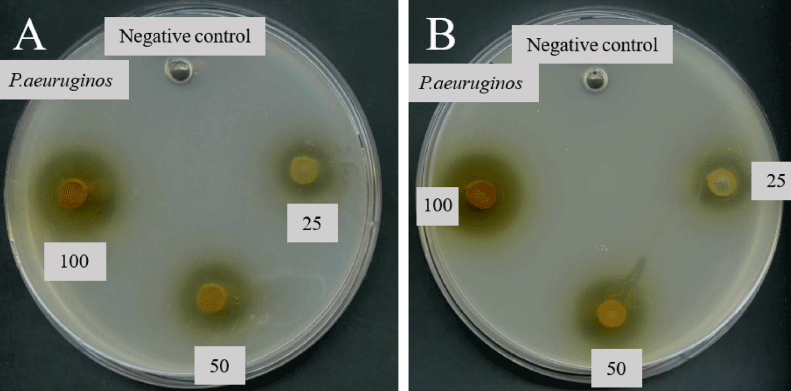

List of Articles
Food Engineering Progress. Vol. 21, No. 2, 2017
Article

Purification of Alginate Lyase from Streptomyces violaceoruber and the Growth Activity of Intestinal Bacteria by Degree of Polymerization of Alginate Hydrolysates
Streptomyces violaceoruber 유래 Alginate Lyase의 정제 및 Sodium Alginate 가수분해 올리고당의 중합도별 Bifidobacterium spp.과 Lactobacillus spp.에 대한 생육활성
Streptomyces violaceoruber 유래 Alginate Lyase의 정제 및 Sodium Alginate 가수분해 올리고당의 중합도별 Bifidobacterium spp.과 Lactobacillus spp.에 대한 생육활성
Food Eng Prog 2017;21(2):103-109.
https://doi.org/10.13050/foodengprog.2017.21.2.103
HTML
PDF
PubReader
https://doi.org/10.13050/foodengprog.2017.21.2.103

The Milling Characteristics of Cutting Type Rice Milling Machine Depending on the Number of a Cutting Roller’s Air Vent and Blowing Velocity
절삭식 정미기의 절삭롤러 통풍구 수와 송풍속도에 따른 정백특성
절삭식 정미기의 절삭롤러 통풍구 수와 송풍속도에 따른 정백특성
Food Eng Prog 2017;21(2):110-115.
https://doi.org/10.13050/foodengprog.2017.21.2.110
HTML
PDF
PubReader
https://doi.org/10.13050/foodengprog.2017.21.2.110

Effects of Die Temperature and Moisture Content on the Quality Characteristics of Extruded Rice with Mealworm
사출구 온도와 수분함량이 갈색거저리(Mealworm) 첨가 압출성형 백미의 품질 특성에 미치는 영향
사출구 온도와 수분함량이 갈색거저리(Mealworm) 첨가 압출성형 백미의 품질 특성에 미치는 영향
Food Eng Prog 2017;21(2):116-125.
https://doi.org/10.13050/foodengprog.2017.21.2.116
HTML
PDF
PubReader
https://doi.org/10.13050/foodengprog.2017.21.2.116
Effect of Millimeter Waves on Quality Characteristics of Cheonggukjang
밀리미터파 처리가 청국장의 이화학적 특성에 미치는 영향
밀리미터파 처리가 청국장의 이화학적 특성에 미치는 영향
Food Eng Prog 2017;21(2):126-131.
https://doi.org/10.13050/foodengprog.2017.21.2.126
HTML
PDF
PubReader
https://doi.org/10.13050/foodengprog.2017.21.2.126

Modeling and Optimization of Dough Properties Using Response Surface Design
반응표면분석법을 이용한 반죽물성의 모델링 및 최적화
반응표면분석법을 이용한 반죽물성의 모델링 및 최적화
Food Eng Prog 2017;21(2):132-137.
https://doi.org/10.13050/foodengprog.2017.21.2.132
HTML
PDF
PubReader
https://doi.org/10.13050/foodengprog.2017.21.2.132

A Study of Salty Enhanceability of Enzymatically Hydrolyzed Isolated Soy Protein
분리 대두 단백 효소가수분해물의 강도평가를 통한 짠맛증진효과 연구
분리 대두 단백 효소가수분해물의 강도평가를 통한 짠맛증진효과 연구
Food Eng Prog 2017;21(2):138-142.
https://doi.org/10.13050/foodengprog.2017.21.2.138
HTML
PDF
PubReader
https://doi.org/10.13050/foodengprog.2017.21.2.138
Evaluation of Antimicrobial Activity of Steamed and Fermented Asparagus cochinchinenesis
증숙 및 발효한 천문동의 항균활성과 특성
증숙 및 발효한 천문동의 항균활성과 특성
Food Eng Prog 2017;21(2):143-149.
https://doi.org/10.13050/foodengprog.2017.21.2.143
HTML
PDF
PubReader
https://doi.org/10.13050/foodengprog.2017.21.2.143

Effects of Moisture Content and CO2 Gas Injection on Physicochemical Properties of Extruded Soy Protein Isolate
수분함량과 CO2 가스 주입에 따른 분리대두단백 압출성형물의 이화학적 특성
수분함량과 CO2 가스 주입에 따른 분리대두단백 압출성형물의 이화학적 특성
Food Eng Prog 2017;21(2):150-157.
https://doi.org/10.13050/foodengprog.2017.21.2.150
HTML
PDF
PubReader
https://doi.org/10.13050/foodengprog.2017.21.2.150

Effect of Semisulcospira libertina Extracts from Different Extraction Processes on Liver Cell Toxicity and Ethanol Metabolism
간세포 독성과 에탄올 대사에서 추출 조건에 따른 다슬기 추출물의 효과
간세포 독성과 에탄올 대사에서 추출 조건에 따른 다슬기 추출물의 효과
Food Eng Prog 2017;21(2):158-166.
https://doi.org/10.13050/foodengprog.2017.21.2.158
HTML
PDF
PubReader
https://doi.org/10.13050/foodengprog.2017.21.2.158
Research Note

Characteristics and Optimization of the Formula of Mashed Potatoes Using Purple-fleshed Potato (Solanum tuberosum L.) by Mixture Design
혼합물 실험계획법을 이용한 유색감자 자영(Solanum tuberosum L.) 매쉬드 포테이토 분말의 혼합비 최적화 및 매쉬드 포테이토의 특성
혼합물 실험계획법을 이용한 유색감자 자영(Solanum tuberosum L.) 매쉬드 포테이토 분말의 혼합비 최적화 및 매쉬드 포테이토의 특성
Food Eng Prog 2017;21(2):167-173.
https://doi.org/10.13050/foodengprog.2017.21.2.167
HTML
PDF
PubReader
https://doi.org/10.13050/foodengprog.2017.21.2.167

Molecular Typing of Leuconostoc citreum Strains Isolated from Korean Fermented Foods Using a Random Amplified Polymorphic DNA Marker
Food Eng Prog 2017;21(2):174-179.
https://doi.org/10.13050/foodengprog.2017.21.2.174
HTML
PDF
PubReader
https://doi.org/10.13050/foodengprog.2017.21.2.174

Determination of Heavy Metals in Sea Salt Using Anodic Stripping Voltammetry
Food Eng Prog 2017;21(2):180-186.
https://doi.org/10.13050/foodengprog.2017.21.2.180
HTML
PDF
PubReader
https://doi.org/10.13050/foodengprog.2017.21.2.180